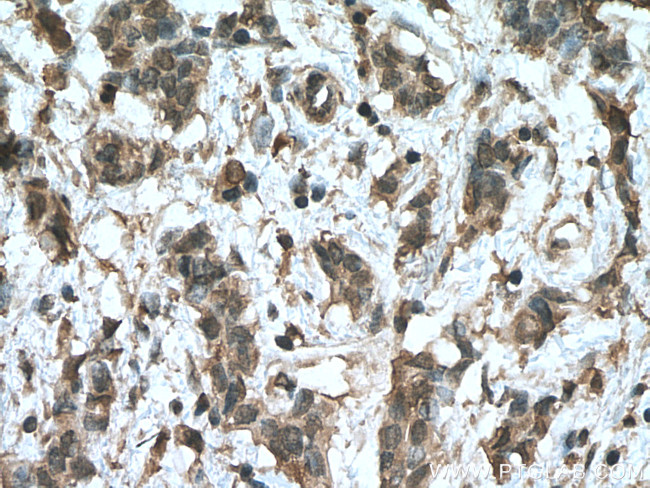
HMBS Antibody in Immunohistochemistry (Paraffin) (IHC (P))

Search
Proteintech
HMBS Monoclonal Antibody (1G12H3)
{{$productOrderCtrl.translations['antibody.pdp.commerceCard.promotion.promotions']}}
{{$productOrderCtrl.translations['antibody.pdp.commerceCard.promotion.viewpromo']}}
{{$productOrderCtrl.translations['antibody.pdp.commerceCard.promotion.promocode']}}: {{promo.promoCode}} {{promo.promoTitle}} {{promo.promoDescription}}. {{$productOrderCtrl.translations['antibody.pdp.commerceCard.promotion.learnmore']}}
产品信息
67456-1-IG
种属反应
宿主/亚型
分类
类型
克隆号
抗原
偶联物
形式
浓度
规格
纯化类型
保存液
内含物
保存条件
运输条件
产品详细信息
Aliquoting is unnecessary for -20°C storage.
靶标信息
PBGD (porphobilinogen deaminase), also designated hydroxymethylbilane synthase, is a cytoplasmic enzyme found in the heme synthesis pathway. PBGD belongs to the HMBS (hydroxymethylbilane synthase) family. Deficiency of PBGD causes errors in pyrrole metabolism, which in turn leads to an inherited autosomal disorder called acute intermittent porphyria (AIP). AIP is characterized by acute attacks of neurological dysfunctions with hypertension, tachycardia, peripheral neurologic disturbances, abdominal pain and excessive amounts of aminolevulinic acid and porphobilinogen in the urine.
仅用于科研。不用于诊断过程。未经明确授权不得转售。
篇参考文献 (0)
生物信息学
蛋白别名: HEM3; HMBS; Hydroxymethylbilane synthase; PBG D; PBG-D; Porphobilinogen deaminase; porphyria, acute; Chester type; Pre-uroporphyrinogen synthase; unnamed protein product; uroporphyrinogen I synthase; uroporphyrinogen I synthetase
基因别名: ENCEP; HMBS; LENCEP; PBG-D; PBGD; PORC; UPS
UniProt ID: (Human) P08397
Entrez Gene ID: (Human) 3145